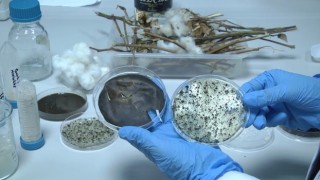
Şanlıurfada öğrencilerden ödüllü çevre dostu projesi

Başkan Acar, Yeni Bir Hizmete Daha Imza Attı
Doğubayazıt Belediye Başkanı Yıldız Acar, ilçede hizmet verecek olan Sağlık Kabini Merkezinin açılışını gerçekleştirdi.
Her fırsatta vatandaşlarla bir araya gelip onların sorun ve taleplerini dinleyen Doğubayazıt Belediye Başkanı Yıldız Acar, ilçede hizmete girecek Sağlık Kabini Merkezinin açılışına katılarak vatandaşlarla buluştu.
Özellikle genç girişimcilerin projelerinde ve ticari hayatlarında başarılı olmaları için her türlü desteği sağlayan Acar, şu ifadelere yer verdi:
"Esnaf dostu bir şehir olmak bizim olmazsa olmazımızdır. Özellikle her türlü meslek dallarının barındığı, adına emek denilen kutsallıkla beraber, ustadan çırağa ve hatta babadan oğula aktarılan bu değerli mesleklerin yaşatılması ve ahi ahlakıyla ahlaklanmış esnafın yanında olmak, bir şehrin yanında olmak demektir. Sağlık konusunda hastalarımızın hastahane sıkıntılarını bir nebze de olsa hafifletecek ve evde yapılması gereken çeşitli tedavilere cevap olacak bu sağlık kabininin hayırlı olmasını diliyorum"

Yorum Yazın